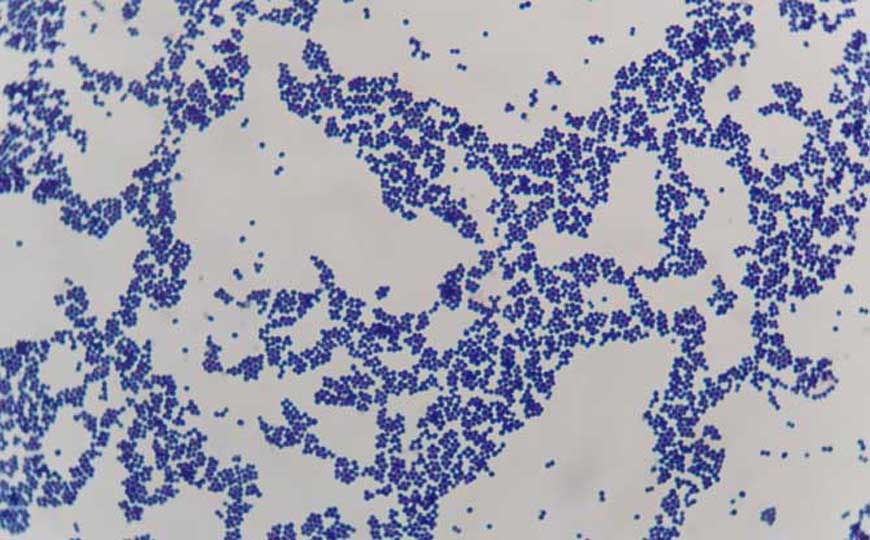
常见的细菌性食物中毒有哪些？

MERS病毒是第6种已知的人类冠状病毒,全称中东呼吸综合...

H7N9是禽流感病毒的一种亚型,学名H7N9型禽流感病毒,2...

HPV病毒是球形DNA病毒,学名人乳头瘤病毒,在生物分类...

HIV是一种能攻击免疫系统的病毒,学名人类免疫缺陷病毒...

SARS病毒是一种单股正链RNA病毒,别称非典型肺炎病毒、...

EM菌是由80余种微生物组成的混合菌,作用机理是和病原...

EB病毒是传染性单核细胞增多症的病原体,别称人类疱疹...

病毒和细菌都是常见的病原体,所谓病原体泛指能引起疾...

RNA病毒是病毒两大类群之一,与DNA病毒相对应,泛指所...

DNA病毒是病毒两大类群之一,与RNA病毒相对应,泛指所...

病毒是一种非细胞生命形态,由核酸和蛋白质外壳组成,...

病毒是一种非细胞生命形态,由核酸和蛋白质外壳组成,...

病毒是一类个体微小、结构简单、只含一种核酸(DNA或RNA...
细菌性食物中毒是指摄入被葡萄球菌、大肠杆菌、副溶血...

真菌是生物最主要的类群之一,既不属于植物,又不属于...

细菌是生物最主要的类群之一,广泛分布于土壤和水中,...

微生物并非生物科学分类中的一个单元,泛指只有依靠光...
电脑版 © 2022 黔ICP备17012036号-4